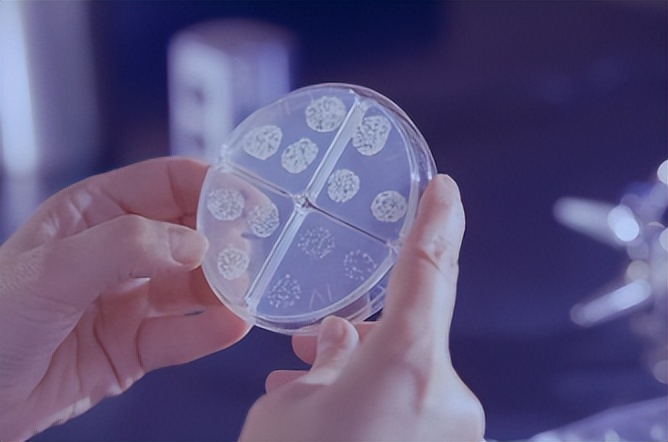
2022包装行业回顾：乌克兰战争、化学回收和生物塑料

在即将过去的2022年,从乌克兰战争和飞涨的能源价格到化学回收辩论和废物出口行动。环境可持续性仍然是主流趋势,但立法改革将一些关键问题—如可重复使用性、回收利用和废物焚烧——推到了前台。联合国的全球塑料条约进入谈判阶段,导致许多国家分裂。这篇文章尽显了2022年度包装行业的重大事件,在冰冷的文字、词汇背后全是包装从业者激烈的情绪,既埋藏有面对不确定性的探索与坚持,又饱含了对包装行业一如既往的热爱与深耕,下面我们通过时间轴来回顾这不平凡的包装之年。
一月
可生物降解的繁荣还是萧条?生物塑料创新面临成本和政策挑战
反塑料立法在全球各国全面生效,促使该行业寻找新的方法来包装食品和饮料产品,同时又不牺牲质量、保质期和卫生。可生物降解材料是一种越来越受欢迎的选择,突出体现在对生物塑料的大规模投资和研发探索,这些生物塑料在使用后会自然分解,不会损害人类或环境健康。

*子骗**,*子骗**塑料着火:土耳其回收商发现纵火设施销毁废物
据研究该国污染和废物犯罪的科学家团队 Microplastic Research Group 称,土耳其各地的回收公司被发现故意烧毁其设施,以此作为廉价销毁危险包装废物的手段。
Ineos 加入 Nextloopp 的食品级聚合物聚丙烯回收项目
Ineos Olefins and Polymers Europe 加入了开创性的聚丙烯回收项目 Nextloopp,支持其交付食品级回收成分。该化学品公司正在策划一个为期两年的关键项目,该项目将在英国建设一个示范工厂,每年生产 10,000 公吨再生聚丙烯。
陶氏投资 Mr. Green Africa 以促进拾荒者经济和灵活的塑料回收
陶氏通过投资其 B 轮融资,进一步加强了与肯尼亚回收公司 Mr.Green Africa 的合作关系,陶氏称这是解决关键废物管理问题的“第一”非洲的差距。全面投入后,这项投资预计将创造约 200 个直接就业机会,影响 5,000 名拾荒者的生活,并让超过 250,000 名消费者参与源头分类计划。
二月

FDA 请求限制食品包装中
因为新发现表明双酚 A (BPA) 对人类健康的危害程度比之前认为的低 100,000 倍,因此公众团体请求美国食品和药物管理局限制食品包装中的双酚 A (BPA) . 由医生、科学家、公共卫生和环境组织组成的联盟呼吁该机构撤销对 BPA 在粘合剂和涂料中的批准,并严格限制其在食品接触塑料中的使用。
欧洲标签紧急情况:FINAT联盟警告北欧国家*工罢**,如果不迅速解决,北欧劳工*工罢**将破坏经济,加上多年来 COVID-19 中断,整个欧洲餐饮、制药和个人护理行业的标签生产大幅减少。报告表明标签材料的交货时间增加了三个月或更长时间。欧洲不干胶标签和窄幅卷筒纸包装行业协会 (FINAT) 警告说,如果*工罢**继续,标签生产不能重回正轨,可能会对整个欧洲大陆的快速消费品产生严重影响。
小袋经济学:非政府组织认为包装存在重大问题
联合利华确定了可负担性造成毁灭性的环境污染。这家快速消费品巨头认为,一次性小袋是必要的,因为它们可以保护产品免受潮湿气候和明亮阳光的影响,并为较贫穷的社区提供购买他们原本买不起的少量产品的机会。
无辜直至有罪:
思慕雪品牌的“漂绿”广告在维权人士被捕后接受调查 Innocent Drinks 受到英国广告标准局的调查,维权人士称这是一项以回收塑料包装为中心的误导性营销活动,相当于“漂绿”。在直接行动组织 Plastics Rebellion 的成员指责 Innocent 试图通过一项名为“小饮料,大梦想”的营销活动来欺骗消费者购买“优质”塑料后,可口可乐公司收到了针对这家公司的投诉。
三月

CEO Jakob A. Mosser 宣布, Coveris 增加了纸质创新,但塑料仍然是关键, Coveris 增加了对纸包装解决方案的关注,但无意退出塑料包装领域。这家欧洲包装制造商主要以其塑料包装和薄膜产品而闻名。
由于俄罗斯威胁要阻止石油和天然气出口,包装行业面临灾难性的经济打击
包装行业被警告说,它可能面临石油和天然气的“灾难性”价格上涨,因为俄罗斯威胁要切断对欧洲的所有供应,包括通过北溪管道,以报复西方因入侵乌克兰而实施的制裁。
与纤维作斗争:随着乌克兰战争升级,林业和纸浆公司停止在俄罗斯的业务
主要纸包装集团和林业标准当局冻结了他们在俄罗斯和白俄罗斯的业务,以抗议入侵乌克兰。预计撤资将对俄罗斯经济造成沉重打击,进一步威胁全球价格上涨并削弱环境可持续性努力。
四月

愚人节?威立雅警告称,英国塑料包装税开始征收,但企业并未意识到
英国塑料包装税于 4 月生效,但根据 YouGov 在代表威立雅。如果塑料包装的生产商或进口商不包括 30% 的回收成分,该税将对每公吨征收 200 英镑(244 美元)的税。
欧盟在绿色交易更新中提议通过新的广告法更严格地限制漂绿
欧盟委员会为欧洲绿色交易提出了一套规则,该规则将加强对漂绿的限制并扩大消费者权利。这些修正案旨在帮助防止误导性广告,并确保包装准确传达产品的耐用性和可修复性。
随着多代人需求的增长,电子商务包装提升了环境可持续*游戏性**
COVID-19 大流行期间出现的电子商务包装需求激增与维持环境可持续性的需要之间的挑战因今年的地缘政治问题而变得更加复杂——尤其是乌克兰战争和膨胀的能源和材料成本。
五月

欺骗史:加州对石化行业的谎言发起“历史性”调查
在“同类首创”的美国州级调查中,加州总检察长罗布·邦塔 (Rob Bonta) 对石油公司“积极”传播数十年来关于塑料及其制品的虚假信息发起了一项重大调查对人类和环境健康的损害。Bonta 调查的核心是指控企业建立了许多虚假的回收计划,包括无法运营或空置的设施以及欺诈性的公共关系活动。
制造循环:时尚如何扰乱循环塑料经济,以及欧盟必须做什么
欧盟政策制定者试图阻止“搭便车”的时尚和汽车企业通过使用回收塑料供应而不贡献公平份额来扰乱循环经济。时尚和汽车公司通过购买由 rPET 生产的饮料包装来提升他们的环境信誉,为公共关系目的创造一种循环的幻觉。Foodservice 执行董事 Martin Kersh 警告说, “虚假声明”预计将在反塑料立法中主导 Packaging Innovations 2022包装协会。Kersh 说,由此产生的问题是,许多包装产品声称不含塑料,但实际上并非如此。
塑料袋税延期在以色列反对*党**中引发分歧
以色列民族自由运动*党**利库德集团投票反对一项旨在延长对消费者塑料袋收费的法案。该法案是由利库德集团自己的一位立法者提交的,但随后遭到结盟的极端正统派系的反对。2016 年通过的一项法律要求顾客在超市为每个塑料袋支付 10 元(0.03 美元)。该立法还禁止分发某些类型的聚合物袋。
六月
谷歌乌克兰支持基金向 Re-Leaf 提供 100,000 美元的落叶包装
奖励乌克兰初创企业 Releaf 是用落叶制成的纸制品的制造商,谷歌乌克兰支持基金向其提供了 100,000 美元的奖励,该基金是在俄罗斯入侵爆发时启动的. 选定的乌克兰企业正在滚动宣布,最高奖励为 100,000 美元的非稀释资金以及持续的谷歌指导、产品支持和云积分。
单体迁移:科学家确定了 388 种危险包装化学品,需要优先淘汰
已知具有致癌、诱变和生殖毒性的塑料单体很容易转移到食品中,使它们与人类暴露高度相关,一项发表在危险材料杂志发现。据研究人员称,其中许多化学物质在欧洲食品包装中很常见。该研究确定了 388 种需要合法淘汰的“高优先级”化学品。
COVID-19 时代的抗菌包装
在COVID-19大流行之后,卫生一直处于包装设计的最前沿。由于包装通常是任何物品的第一个接触点,抗菌包装可为客户提供更高水平的产品保护,以抵御潜在有害微生物。我们谈到了病毒防护、消费者卫生问题以及如何与行业专业人士一起改进当前的研发领域。
七月

加州签署全国最严塑料污染者付费法,反对者质疑环境效益
美国加州签署新《塑料污染生产者责任法案》业者。这份长达 76 页的法案规定,到 2032 年,塑料生产商按重量和物品数量对一次性塑料包装和餐具收取 25% 的费用;将近一半的减少必须来自直接消除塑料包装或改用再利用和再填充系统。该法案还要求,到 2032 年,加州所有一次性包装和餐具,包括非塑料物品,都必须可回收或可堆肥。
印度实施广泛的一次性塑料禁令,因为企业和拾荒者准备应对
破坏世界上每年产生 1100 万吨海洋垃圾。该禁令于 2016 年由总理莫迪首次提出,政府在三天前称赞该禁令的实施是“遏制乱扔和未管理的塑料废物造成的污染的决定性步骤”。
中国研究人员声称进口冷冻食品包装有助于传播 COVID-19
中国研究人员将近 700 例 COVID-19 病例与受污染的冷冻食品包装联系起来,支持冷链食品作为 SARS-CoV-2 传播途径并可能存在风险的猜测区域间的病毒传播。该研究结果发表在《中国疾病预防控制中心周刊》上,与世界卫生组织 (WHO) 的官方声明相矛盾,该声明声称没有证据表明 COVID-19 通过食品包装在人与人之间传播。这是首次有人提出环境对人类的传播源于受污染的进口食品。
欧洲瓦楞纸板制造商在最新报告中揭示了“显着”的二氧化碳排放量
非营利性行业组织欧洲瓦楞纸板制造商联合会 (FEFCO) 报告称,瓦楞纸板的二氧化碳排放量为 491 千克二氧化碳当量 (e/t),与其 2018 年评估中产生的 538 千克二氧化碳当量/吨相比,显示出显着改善。这一结果反映了欧洲瓦楞纸行业及其纸张供应商为减少环境影响所做的持续努力。
PepsiCo Labs 招募了六家全球科技初创公司来“革新”欧洲供应链
PepsiCo Labs 选择了六家科技初创公司在其欧洲供应链上试用新兴解决方案。这些合作旨在实现环境可持续性发展,并于今年在整个非洲大陆开展。这些初创公司在土耳其、比利时和葡萄牙等地进行了试点,试验重点放在四个关键领域:效率和自动化、可持续清洁和卫生、回收和水回收。
八月

韩国科学家将包装中的常见化学物质与代谢疾病联系起来
韩国科学家证明,有害的内分泌干扰化学物质,包括消费品包装中发现的邻苯二甲酸盐和双酚 A (BPA),可能会损害哺乳动物的肝脏并引起代谢疾病,尤其是混合物形式. 中央大学的研究人员评估了有毒的 EDCs 对肝功能和代谢稳态的影响。人类经常通过消费品接触到这些化学物质,包括塑料、铝罐、药品和化妆品。
智利、印度、南非和肯尼亚在英国资助的新项目中探索塑料污染解决方案
UK Research and Innovation 和 WRAP 建立了一个 120 万英镑(140 万美元)的项目,以协助智利、印度、南非和肯尼亚的六项计划在解决难以回收的塑料、发展可重复使用的包装以及在每个国家引入创新的商业模式方面。
减少塑料或分散注意力?英国政府因“惊人的”手提袋收费结果面临绿色清洗反弹
英国环境、食品和农村事务部 (Defra) 公布的数据表明,自引入手提袋收费以来,一次性塑料袋的购买量减少了“惊人的 97%” 2015 年出现在超市。然而,这一自称的成功引发了对塑料消费细微差别的质疑,这些组织和环保组织呼吁采取更全面的方法来减少一次性使用。“从表面上看,Defra 的新统计数据显示了减少一次性塑料制品的巨大成果。但这些数字只是通过讲述一小部分故事来给我们洗绿,”A Plastic Planet 的联合创始人 Sian Sutherland 告诉PackagingInsights。
回收的艰难一面:据报道,针对调查非法废物贸易的记者的袭击激增
据报道,两名独立的自由撰稿人在为 Gezegen24 新闻调查 Türkiye 工业区非法回收业务的指控时遭到袭击,受到死亡威胁,媒体设备被没收文章。环保组织警告说,针对调查涉嫌非法管理材料废物的记者的袭击在世界范围内越来越普遍。
编码废物收集:数字序列化如何为包装商和政府节省数十亿美元
在消费者和制造层面数字化回收和再填充系统可以大大改善废物管理,但政策制定者尚未在纸面上考虑。尽管如此,试验始终表明,数字标记将加强对减少废物工作的参与,并在整个价值链中节省大量资金。英国初创公司 Reward4Waste 的董事长托尼·麦格克 (Tony McGurk) 一段时间以来一直在为英国的数字存款返还计划开发技术。他告诉PackagingInsights,这个概念可以彻底改变管理收集和分类。
EcoPackables 推出来自咖啡副产品的可堆肥电子商务包装,因为 Z 世代将环境放在首位所有现有的解决方案。” EcoPackables 创始人兼首席执行官 Shervin Dehmoubed 与我们谈到了公司包装的环境可持续性优势,以及该行业如何克服对负责任包装的代际观念差异。
九月

欧洲金属行业面临“生死攸关”的冬天,因为能源价格削弱了生产
欧洲金属行业协会敦促欧盟领导人立即采取紧急行动或接受“永久去工业化”。在致欧盟委员会的一封信中,近 50 家组织表示,他们的行业将在今年冬天面临“生死攸关”的时刻。根据荷兰非营利组织塑料汤基金会的一份报告,荷兰在向脆弱国家出口欧盟塑料废物方面名列前茅. 2021 年,荷兰出口了超过 2.11 亿公斤塑料垃圾,其中将近 7000 万公斤运往印度尼西亚,将近 6400 万公斤运往越南。与 2020 年相比,这意味着对脆弱国家的出口增长了两倍。与PackagingInsights 对话,基金会竞选经理 Jurjen de Waal 表示,他对出口的增长感到惊讶。“这令人震惊,因为我们知道这些国家的大量垃圾管理不善,导致了环境和公共卫生灾难。”
泰国宣布到 2025 年全面禁止塑料垃圾进口以“保护国家”
在分三阶段的计划中,泰国宣布到 2025 年全面禁止塑料垃圾进口。自然资源和环境部长 Varawut Silpa-archa 表示,自 2020 年以来一直在讨论,他认为此举是必要的,他说,“我们需要保护我们的国家。” “泰国绝不能成为塑料垃圾的倾倒地。到未来三年结束时,我们将不允许从世界各地进口任何塑料废料,”他说。
*权人**观察在土耳其塑料回收设施发现童工、剥削和接触有毒化学品
儿童、无证移民和寻求庇护者被迫在处理大部分西方国家垃圾的土耳其塑料回收行业的危险条件下工作。这些是*权人**观察报告的主要发现,该报告详述了该国作为较发达国家的废物处理场的地位所造成的人力成本。
欧洲零废物警告说,塑料热解威胁到巴黎协定的气候变化目标 欧洲
零废物 (ZWE) 发表的一项研究发现,塑料包装热解产生的温室气体排放量是机械回收的九倍。因此,ZWE 敦促 EC 和行业领导者优先考虑扩大机械回收,以满足对回收内容不断增长的需求。
全球塑料污染条约:路透社揭露美国招募盟友推动自我监测议程据路透社报道,美国成立了一个联盟来影响今年达成一致的联合国全球塑料污染条约的参数。据称,乔·拜登总统的政府招募日本和澳大利亚与 8 月成立的欧洲国家联盟竞争。根据披露的信息,美国对该条约的雄心类似于允许各国自我监测的巴黎气候协定。
十月

麦当劳、雀巢和达能等 9 家食品公司因在法国因塑料废弃物问题而收到法律 通知” 管理其产品造成的塑料废物影响的计划。根据法国法律,这些计划是强制性的,该联盟表示,涉及的公司要么没有打扰,要么没有制定足够的计划。
绿色和平组织猛烈抨击可口可乐“莫名其妙”的 COP27 赞助
可口可乐公司宣布与埃及外交部合作赞助第 27 届年度联合国气候变化缔约方大会 (COP27) 后引发了嘲笑。会议于 11 月 6 日至 18 日在埃及沙姆沙伊赫举行。美国绿色和平组织表示,“令人困惑的是,世界上最大的塑料污染者”赞助了此次活动。
Danimer Scientific 首席执行官:拜登总统的行政命令和美国生物塑料的未来
在美国总统乔·拜登发布推进美国生物技术和生物制造的行政命令之后,我们与 Danimer Scientific 首席执行官 Stephen Croskrey 讨论了将推动生物塑料市场发展的新举措和资金。这是政府减少碳排放、降低价格、加强供应链和促进能源安全的努力的一部分。
比利时研究人员发现使用热解油的新化学回收技术
比利时根特大学的研究人员发现,使用热解作为先进的塑料废物回收系统可以缩小石化塑料生产与报废废物管理(如降级循环、焚烧和回收)之间的差距填埋场。
中国打击过度包装持续严打
国务院办公厅印发关于进一步加强商品过度包装管控的通知,要求进一步防范商品过度包装。此外,中国发展网宣布,到2025年底,全国邮政快递网点全面禁止使用不可降解塑料包装袋、塑料胶带和一次性塑料编织袋。
十一月

美国初创公司 Protein Evolution 获得 2000 万美元用于扩大酶塑料回收的规模
美国初创公司 Protein Evolution 建立了据称是世界上第一家酶塑料回收企业,获得了 2000 万美元的初始资金。该小组将人工智能与合成生物学相结合,绘制出数千万种能够将塑料垃圾转化为可重复使用化学品的酶。它声称,这个过程可以无限重复。
Pulpac 获得 3100 万欧元的资金以将干模纤维推向全球
PulPac 筹集了 3100 万欧元(3100 万美元)的投资以扩大其干模纤维技术生产。资金来自一个跨行业集团,包括 Aliaxis、Stora Enso、Amcor Ventures 和 Teseo Capital。我们与 PulPac 的首席执行官 Linus Larsson Green 讨论了这笔钱将如何使用。
欧洲协会表示,欧盟包装立法可能削弱行业并危及数百万个工作岗位
价值链上 50 多个欧洲包装协会发表声明,对欧盟委员会 (EC) 的包装和包装废弃物指令修订计划表示“严重关切” (PPWD)。这些团体指责欧共体忽视回收在实现循环经济中的作用。
欧盟委员会敦促在废物指令修订迫在眉睫时*制抵**行业的“生存威胁”游说
一群领先的企业代表以及消费者和环境组织呼吁欧盟委员会不要屈服于反对计划修订 PPWD 的行业游说压力。欧洲环境局废物和监管高级政策官 Piotr Barczak 告诉 PackagingInsights,游说说法是“从空中挑选出来的”,工业变革是欧盟绿色协议道路上必要且不可避免的演变。
十二月

淡化 PPWD 修订激怒了环保主义者和行业团体
在多次泄露草案后,EC 发布了 PPWD。在包装行业的强烈抗议之后,该指令淡化了其预期的再利用目标——这激怒了环保主义者。回收内容包装的目标最显着的下降是一次性塑料饮料瓶从 50% 降低 30%,所有其他类型的塑料包装从 45% 降低 35%。 世界舞台上的拾荒者:塑料污染条约谈判正式承认非正式收集者联合国全球塑料条约国际谈判委员会。
持有 8 万亿美元资产的投资公司要求全球最大的化学品企业减少 PFAS
共有 47 家持有超过 8 万亿美元资产的投资者和资产管理公司致信全球最大化学品生产商的首席执行官,披露他们生产的所有危险化学品的数量。这封信要求采取改进措施来管理 PFAS,也称为“永久化学品”。这封由 Aviva Investors 和 Storebrand Asset Management 牵头的公开信发布之际,瑞典非营利组织 ChemSec 发布了第三次年度 ChemScore 排名,强调该行业在阻止“正在出现的全球危机”方面无所作为。
文章来源:生物基能源与材料